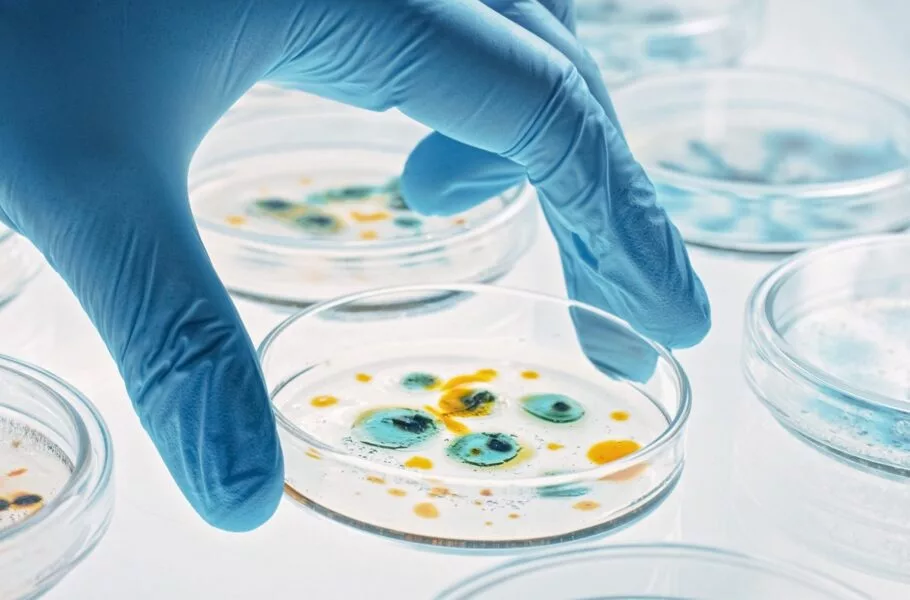

دستاورد محققان: هوش مصنوعی مولدی که میتواند آنتیبیوتیکهای جدید طراحی کند
محققان دانشگاه مکمستر کانادا و دانشگاه استنفورد آمریکا یک مدل هوش مصنوعی مولد جدید ابداع کردهاند که میتواند میلیاردها مولکول آنتیبیوتیک جدید طراحی کند. این آنتیبیوتیکها ارزانقیمت هستند و ساخت آنها در آزمایشگاه آسان است.
براساس مقاله منتشرشده در نیچر، محققان یک مدل هوش مصنوعی مولد جدید به نام «SyntheMol» ایجاد کردهاند که میتواند آنتیبیوتیکهای جدیدی برای مقابله با باکتریها طراحی کند. از این هوش مصنوعی میتوان برای جلوگیری از گسترش «اسینتوباکتر بومانی» – یکی از خطرناکترین باکتریهای مقاوم به آنتیبیوتیک در جهان – کمک گرفت.
هوش مصنوعی مولد برای تولید آنتیبیوتیکهای جدید

با گسترش جهانی باکتریهای مقاوم به دارو، نیاز فوری به آنتیبیوتیکهای جدید ایجاد شده است؛ حتی روشهای مدرن برای ایجاد ترکیبات شیمیایی جدید نیز محدود یا گرانقیمت هستند. بهطور کلی، آنتیبیوتیکها یک داروی انحصاری تلقی میشوند، یعنی بهمحض اینکه یک آنتیبیوتیک در آزمایشگاه تولید میشود، باکتریها بهسرعت تکامل مییابند تا در برابر آن مقاومت کنند. به همین دلیل باید با روشی سریع و کمهزینه بهطور مدام آنتیبیوتیکهای جدید تولید کرد. اینجاست که هوش مصنوعی نقش مهمی ایفا میکند. هوش مصنوعی SyntheMol میتواند 132 هزار قطعه مولکولی با ماهیتهای مختلف را از طریق 13 واکنش شیمیایی ترکیب کند. بهعبارتی، با این هوش مصنوعی میتوان 30 میلیارد ترکیب مختلف مولکولی طراحی و تولید کرد.
محققان از این هوش مصنوعی برای ساخت آنتیبیوتیک اسینتوباکتر بومانی استفاده کردهاند. مدل SyntheMol نهتنها مولکولهای جدیدی طراحی میکند که خود میتواند به ساخت دارویی امیدوارکننده منتهی شود، بلکه دستورالعملهایی را برای نحوه ساخت هر ترکیب جدید نیز در اختیار محققان قرار میدهند. چنین دستورالعملهایی به شیمیدانها کمک میکند تا ترکیبات تولیدشده با هوش مصنوعی بسازند.

![اسپاتیفای از هوش مصنوعی جدیدی برای ساخت پادکست رونمایی کرد [تماشا کنید] اسپاتیفای از هوش مصنوعی جدیدی برای ساخت پادکست رونمایی کرد [تماشا کنید]](https://farsigeek.com/wp-content/uploads/2026/05/d8a7d8b3d9bed8a7d8aadb8cd981d8a7db8c-d8a7d8b2-d987d988d8b4-d985d8b5d986d988d8b9db8c-d8acd8afdb8cd8afdb8c-d8a8d8b1d8a7db8c-d8b3d8a7d8ae_6a111ab1a7aad-510x365.webp)








